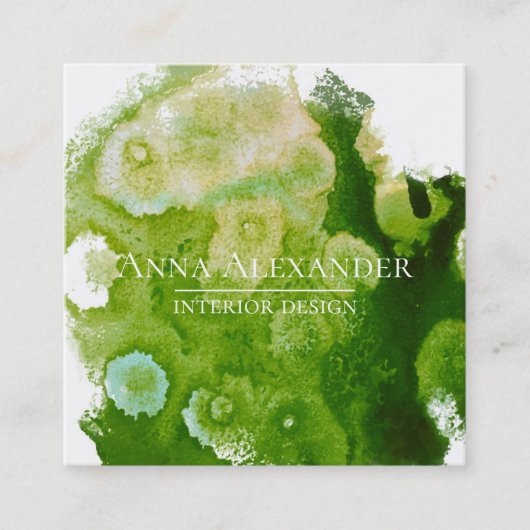
Kunstmatige groene Abstracte Waterverf Vierkante Visitekaartje (Voorkant)

€ 37,35
per verpakking van 100
Kunstmatige groene Abstracte Waterverf Vierkante Visitekaartje
Bekijk productdetailsOver Visitekaartjes
Aangeboden door
Over dit ontwerp
Kunstmatige groene Abstracte Waterverf Vierkante Visitekaartje
Oorspronkelijk schilderij van Margaret Dill.
Ontwerp van international designer
Klant beoordelingen
4.7 van 5 sterren beoordeling51 aantal beoordelingen
51 Reviews
Beoordelingen voor identieke producten
5 van 5 sterren beoordeling
Door Robby T.31 maart 2020 • Geverifieerde aankoop
Visitekaartje, maat: Amerikaans, 8,9 x 5,1 cm,papier: Standaard Halfglanzend, hoeken: Vierkant
Zazzler recensent programma
zijn geld waard de kaartjes zijn zo als je ze zelf samenstelt online echt super product
we gaan er zeker nog bestellen. super afdruk het kan niet beter zijn zeker een aanrader
4 van 5 sterren beoordeling
Door J.6 augustus 2020 • Geverifieerde aankoop
Visitekaartje, maat: Amerikaans, 8,9 x 5,1 cm,papier: Signature Mat, hoeken: Vierkant
Zazzler recensent programma
Ik ben heel tevreden over zazzle. Ontzettend veel keuze in allerlei mooie ontwerpen. Ik zocht iets met een libelle en vond precies dat wat ik in gedachten had. Ik kon alleen geen andere kleur papier kiezen.
Makkelijk zelf te bewerken en een snelle levering. Het is een mooie kwaliteit papier, de afdruk staat er heel netjes op. De kaartjes worden geleverd in een mooi doosje.
Ik ben erg blij ermee
4 van 5 sterren beoordeling
Door Mooi I.27 december 2023 • Geverifieerde aankoop
Visitekaartje, maat: Amerikaans, 8,9 x 5,1 cm,papier: Signature Mat, hoeken: Vierkant
Zazzler recensent programma
Mooie uitstraling en helemaal aanpasbaar
Voor een mooi bedrag. Zoals ik zelf in mijn hoofd had, heel blij mee
Tags
Andere Info
Product ID: 240472338165457618
Ontworpen op: 15-4-2018 12:31
Rating: G
Recent bekeken items



